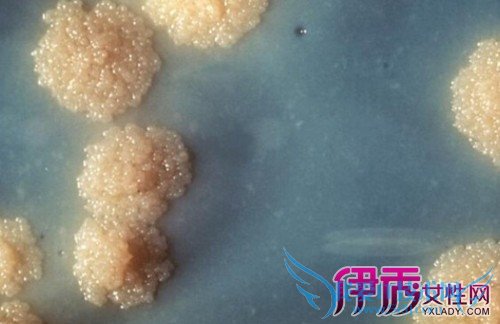

晚期潜伏梅毒怎么治疗 潜伏梅毒中医治疗方法【图】
时间:2016-03-21 19:20 来源: 我爱IT技术网 作者:伊秀生活
晚期潜伏梅毒怎么治疗
晚期潜伏梅毒怎么治疗?晚期潜伏梅毒应根据病人的具体情况采取不同的治疗措施,下面为您介绍不同情况下晚期潜伏梅毒的不同治疗原则。潜伏梅毒中医治疗方法有哪些?

晚期潜伏梅毒怎么治疗
晚期潜伏梅毒怎么治疗?晚期潜伏梅毒应根据病人的具体情况采取不同的治疗措施,下面为您介绍不同情况下晚期潜伏梅毒的不同治疗原则。潜伏梅毒中医治疗方法有哪些?
(1)血清阴转病人:如晚期活动梅毒时期已治疗的病人可不再治疗,如再发生病变应再治疗一次。
(2)血清由阳性转阴性病人:活动梅毒时期已完成治疗的不再治疗,如有病变再发生,再治疗一次。(3)血清由阴性转阳性病人:无论活动时期是否完成治疗,均需再治疗一次。
(4)血清阳性病人:无论活动梅毒时期是否治疗,均需再治疗一次。
以上就是不同情况下晚期潜伏梅毒的不同治疗原则,建议您根据自己的情况采取相应的治疗原则,希望以上内容对您有所帮助。
晚期潜伏梅毒怎么治疗
晚期潜伏梅毒怎么治疗?晚期潜伏梅毒应根据病人的具体情况采取不同的治疗措施,下面为您介绍不同情况下晚期潜伏梅毒的不同治疗原则。潜伏梅毒中医治疗方法有哪些?

一、辩证选方
1. 疫毒留滞 治法:祛风散血、解毒清火。方药:黄连解毒汤加减。黄连15g,黄芩15g,黄柏20g,山栀15g。表证明显加双花、连翘;皮疹出现加生地、马齿苋;热重加水牛角、大黄。
2. 秽疮结毒 治法:凉血解毒、化瘀散结。方药:五味消毒饮加味。公英20g,双花25g,野菊花20g,地丁20g,天葵15g。加蟾酥6g,大黄 15g,犀角 0.6g。 3. 小儿遗毒 治法:清血解毒,活血祛风。 方药;升麻解毒汤加味。升麻5g,鲜皂角刺5g,土茯苓7.5g。加苍术,陈皮,马齿苋,黄柏。
二、专方验方
1. 杨梅疮试验方:全虫10个,大蜈蚣10g,双花120g,生大黄120g。清水煎,频服。
2.土茯苓1500g,生黄芪500g,当归400g。先将土茯苓煎汤,取黄花、当归拌匀微炒,干磨为末,蜜为丸。每次15g,每日3次,一剂当效。
三、其它疗法
外治法;
1. 黄柏、雄黄各 6g,孩儿茶 9g,没药、轻粉、粉霜、枯研各 3g,丹砂 15g,龙脑 0.9g,蜗牛10个。共为细末,猪胆调搽,每日数次。
2.轻粉、龙脑、黄柏(炒)、胡料各6g,百花霜、黄丹(水飞)、生甘草各9g,蚯蚓粪(火焙干)30g。各研细末,点擦。 潜伏梅毒西医治疗方法- 评论列表(网友评论仅供网友表达个人看法,并不表明本站同意其观点或证实其描述)
-
